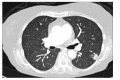

Fatal infections in older patients with inflammatory bowel disease on anti-tumor necrosis factor therapy
- PMID: 29142521
- PMCID: PMC5683984
- DOI: 10.5217/ir.2017.15.4.524
Fatal infections in older patients with inflammatory bowel disease on anti-tumor necrosis factor therapy
Abstract
Anti-tumor necrosis factor (anti-TNF) is highly effective in inflammatory bowel disease (IBD); however, it is associated with an increased risk of infections, particularly in older adults. We reviewed 349 patients with IBD, who were observed over a 12-month period, 74 of whom had received anti-TNF therapy (71 patients were aged <60 years and 3 were aged ≥60 years). All the 3 older patients developed serious infectious complications after receiving anti-TNFs, although all of them were also on concomitant immunosuppressive therapy. One patient developed disseminated tuberculosis, another patient developed cholera diarrhea followed by nosocomial pneumonia, while the third patient developed multiple opportunistic infections (Pneumocystis pneumonia, cryptococcal septicemia and meningitis, Klebsiella septicemia). All 3 patients died within 1 year from the onset of the infection(s). We recommend that anti-TNF, especially when combined with other immunosuppressive therapy, should be used with extreme caution in older adult patients with IBD.
Keywords: Anti-tumor necrosis factor; Elderly patients; Serious infections.
Conflict of interest statement
Conflict of interest: None.
Figures

References
-
- Dignass A, Van Assche G, Lindsay JO, et al. The second European evidence-based consensus on the diagnosis and management of Crohn’s disease: current management. J Crohns Colitis. 2010;4:28–62. - PubMed
-
- Dignass A, Lindsay JO, Sturm A, et al. Second European evidence-based consensus on the diagnosis and management of ulcerative colitis part 2: current management. J Crohns Colitis. 2012;6:991–1030. - PubMed
-
- Hanauer SB, Feagan BG, Lichtenstein GR, et al. Maintenance infliximab for Crohn’s disease: the ACCENT I randomised trial. Lancet. 2002;359:1541–1549. - PubMed
-
- Schreiber S, Khaliq-Kareemi M, Lawrance IC, et al. Maintenance therapy with certolizumab pegol for Crohn’s disease. N Engl J Med. 2007;357:239–250. - PubMed
LinkOut - more resources
Full Text Sources
Other Literature Sources